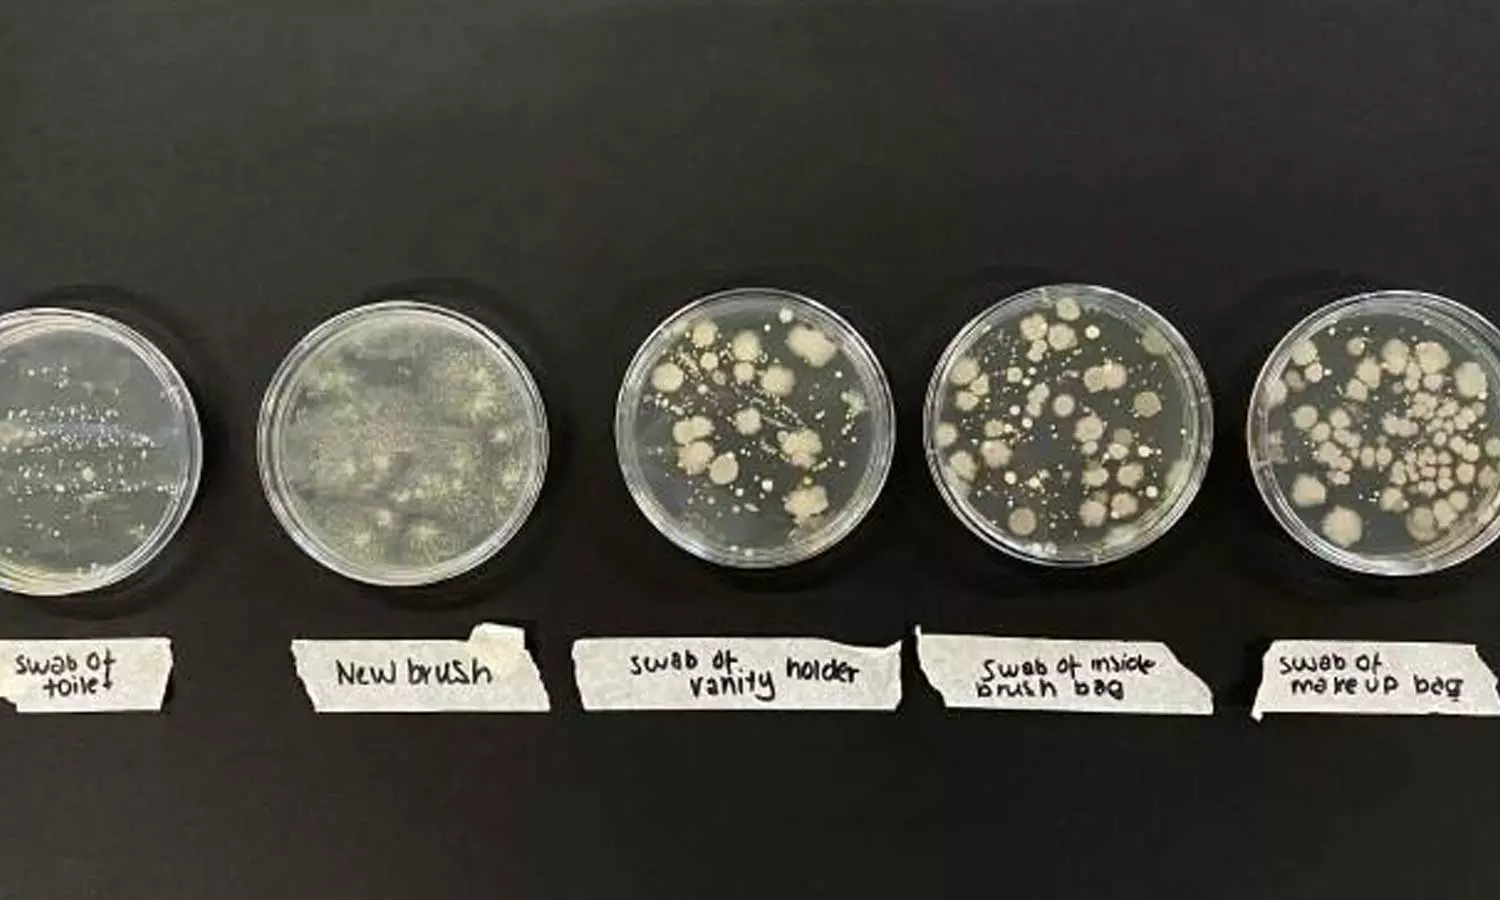

മേക്കപ്പ് ബ്രഷുകൾ സ്ഥിരമായി ഉപയോഗിക്കുന്നവരാണോ....? ടോയ്ലെറ്റ് സീറ്റിനേക്കാൾ കൂടുതൽ ബാക്ടീരിയകൾ അടങ്ങിയിട്ടുണ്ടെന്ന് പഠനം
|വൃത്തിയുള്ളതും വൃത്തിയില്ലാത്തതുമായ മേക്കപ്പ് ബ്രഷുകൾ രണ്ടാഴ്ചത്തെ പഠനത്തിന് ഗവേഷകർ വിധേയമാക്കിയിരുന്നു
സ്ഥിരമായി മേക്കപ്പ് ബ്രഷുകൾ ഉപയോഗിക്കുന്നവർ കരുതിയിരിക്കുക. ഉപയോഗ ശേഷം കൃത്യമായ ഇടവേളകളിൽ അവ വൃത്തിയാക്കാതിരുന്നാൽ അപകടമാണെന്ന് പുതി പഠനറിപ്പോർട്ട്. ശരിയായി വൃത്തിയാക്കാത്ത മേക്കപ്പ് ബ്രഷുകളിലുള്ള ബാക്ടീരിയകളുടെ അളവ് ടോയ്ലറ്റ് സീറ്റിലുള്ള ബാക്ടീരിയോളമോ അതിൽ കൂടുതലോ വരുമെന്ന് കോസ്മെറ്റിക് ടൂൾ ബ്രാൻഡായ സ്പെക്ട്രം കളക്ഷൻസ് നടത്തിയ പഠനം സൂചിപ്പിക്കുന്നതായി ഇന്ത്യ ടുഡേ റിപ്പോർട്ട് ചെയ്തു. എവിടെ സൂക്ഷിച്ചാലും വൃത്തിയില്ലാത്ത മേക്കപ്പ് ബ്രഷുകളിൽ ഭയാനകമായ അളവിൽ ബാക്ടീരിയകൾ ഉണ്ടാകാൻ സാധ്യതയുണ്ടെന്നും പഠനം സൂചിപ്പിക്കുന്നു.
വൃത്തിയുള്ളതും വൃത്തിയില്ലാത്തതുമായ മേക്കപ്പ് ബ്രഷുകൾ രണ്ടാഴ്ചത്തെ പഠനത്തിന് ഗവേഷകർ വിധേയമാക്കിയിരുന്നു. മേക്കപ്പ് ബ്രഷുകൾ കിടപ്പുമുറി, മേക്കപ്പ് ബാഗ്, മേശയുടെ ഡ്രോയർ തുടങ്ങി നിരവധി സ്ഥലങ്ങളിൽ സൂക്ഷിച്ചു. തുടർന്നാണ് ഇവയിലെ ബാക്ടീരയുടെ അളവ് പരിശോധിച്ചത്.
ബാക്ടീരിയകളുടെ എണ്ണം ടോയ്ലറ്റ് സീറ്റിനേക്കാൾ തുല്യമോ അതിലധികമോ ആയിരുന്നു. വൃത്തിയാക്കാത്ത ബ്രഷുകളെ അപേക്ഷിച്ച് വൃത്തിയുള്ള മേക്കപ്പ് ബ്രഷുകളിൽ ബാക്ടീരിയയുടെ സാന്നിധ്യം വളരെ കുറവാണെന്നും കണ്ടെത്തി. വൃത്തിയാക്കാത്ത മേക്കപ്പ് ബ്രഷുകൾ ഉപയോഗിക്കുന്നത് ചർമ്മരോഗങ്ങൾക്ക് കാരണമാകുമെന്ന് കോസ്മറ്റിക് വിദഗ്ധയായ കാർലി മുസ്ലെ പറയുന്നു.
എങ്ങനെ മേക്കപ്പ് ബ്രഷ് വൃത്തിയാക്കാം..
ഒരു കപ്പ് വെള്ളത്തിൽ രണ്ടോ മൂന്നോ തുള്ളി ലിക്വിഡ് സോപ്പ് ഒഴിക്കാം. അതിൽ എല്ലാ ബ്രഷുകളും അതിൽ ഇട്ടുവെക്കുക. അൽപ സമയത്തിന് ശേഷം ഓരോ ബ്രഷും നന്നായി കഴുകുക. ബ്രഷിൽ മേക്കപ്പ് ഉൽപ്പന്നങ്ങൾ അവശേഷിക്കുന്നില്ലെന്ന് ഉറപ്പാക്കുക. വൃത്തിയുള്ള തൂവാല കൊണ്ട് തുടച്ച് ഉണക്കിയെടുക്കുക.